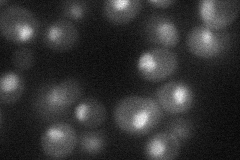
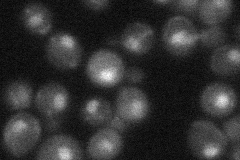
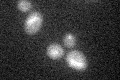

View description
Subunit of the THO complex, which connects transcription elongation and mitotic recombination, and of the TREX complex, which is recruited to activated genes and couples transcription to mRNA export; involved in telomere maintenance
Localization:
Intensity:
Fold change:
Significance:
-
C’ GFP library in SD

below threshold17.02 -
N' NOP1pr-GFP in SD

nucleus45.6922 -
N' TEF2pr-mCherry in SD
nucleus32.1234 -
N' NATIVEpr-GFP in SD
punctate,nucleus27.0296 -
N' TEF2pr-VC and Cyto-VN in SD

nucleus30.0816 -
C’ GFP library in SD+DTT
cytosol17.051No -
C’ GFP library in SD+H2O2

cytosol16.910.99No -
C’ GFP library in Starvation Media

cytosol14.320.84No -
C’ GFP library on the background of Pup2-DaMP

below threshold -
C’ GFP library on the background of CCT mutant

below threshold22.88251.3437No
